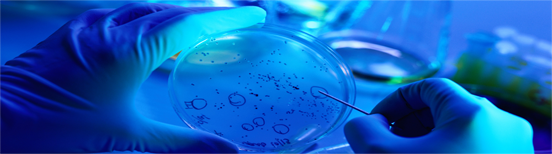

院校主动定位和瞄准国家与人民需求,充分发挥自身“医教研产防”五位一体协同创新特色机制,大力促进科技成果转化与产业化,使科技成果快速转化为国家急需的医药产品,更好地为人民健康服务。
建院伊始,由中国医学科学院研发的一批重大科技成果即成功实现了产业化:中国第一支青霉素的诞生及应用;脊髓灰质炎减毒活疫苗糖丸研制成功并向全国推广使用等,六十年来为保障人民健康作出了巨大贡献。
近年来,依托院校雄厚的科研实力,科技产业发展取得较大进展。我国第一个具有国际自主知识产权的I类抗肝炎合成创新药——百赛诺成功上市并出口“一带一路”多个国家,为众多肝病患者的治疗带来福音,也为我国创新药品的产业化及国际化提供了宝贵经验;国内外首创的中药I类新药人工麝香及其产业化,是我国中药新药和珍稀濒危动物药材代用品研究的重大突破,对中药现代化和中医药行业的科技进步起到了强有力的推动作用;医学生物学研究所自主研发的全球首个Sabin株脊髓灰质炎灭活疫苗单苗、全球首个肠道病毒71型灭活疫苗(人二倍体细胞)相继上市,标志着我国在新型疫苗研究领域中的创新成果达到了国际先进水平,对提高我国应对突发传染病的应急响应能力、保障人民健康和生命安全具有重要意义;医药生物技术研究所历时30年研发的可利霉素于2019年6月获批国家一类新药,将更好地服务于我国医疗健康事业。
展望未来,院校将继续以保障人民健康为己任,加快促进科技成果转化,着力培育成果转化优势龙头企业,实现科技产业中高速发展向中高端转型,不断满足人民群众的健康需求。